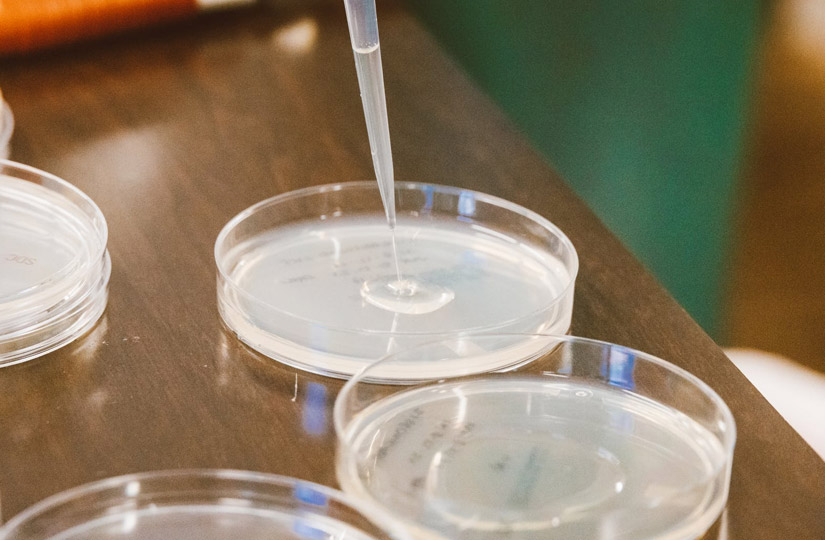

Препараты витамина P
Для восполнения необходимой человеческому организму нормы биофлавоноидов при развитии болезни назначают витаминосодержащие лекарственные средства. Существуют следующие препараты витамина P:
- рутозид;
- рутин;
- аскорутин;
- урутин;
- пефлавит.
Форма выпуска рутина, аскорутина, пефлавита – таблетки, урутина – раствор для инъекций, рутозида – таблетки и гель. Формула рутозида представляет собой гликозид кверцетина. Инструкция по употреблению препарата приводит показания для применения лекарственного препарата: варикоз, тромбофлебит, геморрой, отечность.
Препараты биофлавоноидов назначают:
- при арахноидите;
- при артериальных гипертензиях;
- при геморрагических диатезах;
- при гломерулонефрите;
- при капилляротоксикозах;
- при кори;
- при кровоизлияниях в сетчатку глаза;
- при ревматизме;
- при септическом эндокардите;
- при скарлатине;
- при сыпном тифе;
- при тромбоценической пурпуре.
Симптомы нехватки витаминов P
От недостатка витамина Р страдают внутренние органы, а уже потом возникают внешние признаки авитаминоза. Слишком тонкие капилляры провоцируют заболевания сосудов, во время ходьбы человек начинает испытывать боль в ногах, плечевом поясе, даже при малейших физических нагрузках организм испытывает сильную усталость.
Признаками авитаминоза, а точнее острого дефицита витамина Р, являются носовые кровотечения, воспаленные десна, темные пятна на коже и выпадающие волосы.
Потребность в рутине значительно возрастает в случаях, когда организм попадает под ионизирующее излучение, при длительном приеме антикоагулянтов, тяжелых условиях работы в жарком, душном помещении, активных занятиях спортом, кори, скарлатине, ревматизме, отравлении химикатами, содержащими свинец или хлороформ.
Предупреждение! Бездумный прием витаминов навредит организму ничуть не меньше, чем их нехватка – избыток рутина запросто может спровоцировать гипер- или гиповитаминоз.
Гипервитаминоз
Как утверждают врачи, гипервитаминоз витамина Р практически невозможен, так как его излишки без проблем выводятся организмом. Но чрезмерное употребление продуктов с повышенным содержанием витамина Р может вызвать аллергическую реакцию.
Суточное употребление витамина Р составляет 250 миллиграммов для взрослого человека и 150 для ребёнка. Посчитать самостоятельно количество вещества вряд ли удастся.
Если склонности к аллергии нет, то смело включайте как можно больше в свой рацион продуктов, в которых содержится витамин Р, ведь фрукты и овощи богаты и другими полезными элементами.
Вопрос-ответ
Есть ли побочные действия у цитаминов?
Цитамины – это комплексы биорегуляторных пептидов, получаемые из органов и тканей животных. Пептиды животных идентичны человеческим и подвергаются нескольким уровням очистки, но в редких случаях могут встречаться аллергические реакции на белки, входящие в состав цитаминов.
С какого возраста можно применять цитамины?
Цитамины разработаны с целью профилактики и коррекции возрастных изменений различных органов и тканей, поэтому, как правило, назначаются взрослым пациентам. Применение цитаминов в профилактических целях помогает поддержать и укрепить здоровье, предотвратить развитие заболеваний и достигнуть активного долголетия.
Что входит в состав цитаминов?
По своему составу цитамины являются комплексами натурального происхождения, содержащими белки, нуклеиновые кислоты, микроэлементы, минеральные вещества (медь, цинк, магний, марганец, железо, фосфор, калий, кальций, натрий и др.) и витамины (тиамин, рибофлавин, ниацин, ретинол, токоферол и др.), представленные в легкоусвояемой форме, что обусловливает их высокую пищевую и физиологическую ценность.
Как действуют цитамины?
Механизм биологического действия цитаминов заключается в особенности веществ, которые лежат в основе препарата – пептидов. Пептиды – это биологически активные вещества, представляющие собой белковое соединение из нескольких аминокислот, они регулируют внутриклеточные процессы и обеспечивают нормальную работу органов и тканей. Все пептиды имеют свою «специализацию»: попадая в организм человека, они поступают именно в те органы, для которых предназначены. Встретившись со стареющей клеткой, для которой зачастую характерны повреждения структуры, пептиды насыщают ее белковым «коктейлем», восстанавливая ее функцию. Встретившись с молодыми клетками, пептиды посредством участия в обменных процессах способствуют их «подготовке» к полноценному развитию и становлению в зрелые формы. Посредством участия в процессах клеточного обмена пептиды оказывают положительное влияние на функционирование взрослых здоровых клеток, предотвращая их преждевременное старение.
Таким образом, цитамины обладают не только восстанавливающим свойством в отношении старых, повреждённых клеток, но также и профилактическим эффектом в отношении молодых, здоровых клеток.
Можно ли применять цитамины с другими лекарственными средствами?
Цитамины совместимы с любыми питательными и лекарственными веществами, в том числе и с гормональными средствами. В клинических исследованиях и последующей медицинской практике цитамины активно использовались в комплексной терапии различных состояний. За время практического применения несовместимости с другими лекарственными препаратами не выявлено.
Есть ли противопоказания для приема цитаминов?
В настоящее время противопоказаниями для приема цитаминов является только беременность и период грудного вскармливания, поскольку для этих групп не проводились клинические исследования действия цитаминов, а также противопоказанием является непереносимость компонентов препарата.
Как понять, какие цитамины нужны организму?
На сегодняшний день существует 17 цитаминов, предназначенных для различных органов и систем. Все пептидные биорегуляторы работают адресно. Цитамины могут активировать процесс синтеза белка только в том органе, из которого он был получен. Это называется тропность или тканеспецифичность. Овариамин (цитамин для яичников) запускает метаболизм клеток яичников, Корамин (цитамин для миокарда) регулирует метаболизм клеток сердца и так далее. Определить, какой цитамин применим для Вас, поможет комплексный тест и консультация лечащего врача.
Можно ли принимать несколько цитаминов одновременно?
Да, прием нескольких цитаминов одновременно возможен. Мы рекомендуем проконсультироваться с лечащим врачом, прежде чем начинать прием нескольких цитаминов сразу.
Показания к применению
У взрослых в комплексной терапии:
– инфаркта мозга;
– последствий цереброваскулярных болезней (инфаркта мозга, церебрального атеросклероза);
– токсической и гипоксической энцефалопатии при острых и хронических отравлениях, эндотоксикозах, посленаркозном угнетении сознания, а также для профилактики и лечения гипоксической энцефалопатии при кардиохирургических операциях с использованием искусственного кровообращения, для профилактики когнитивных расстройств после обширных хирургических вмешательств у пациентов пожилого
возраста.
У детей
У детей (в том числе недоношенных со сроком гестации 28–36 недель) в комплексной терапии в периоде новорождённости:
– при церебральной ишемии.
Авитаминоз. Нехватка витамина Р
О важности витамина Р говорит тот факт, что его дефицит вызывает достаточно тяжёлые последствия. Это выражается в болезненных симптомах, появление которых негативно сказывается на здоровье и самочувствии человека
Появляется боль в плечах и конечностях, чувство быстрой утомляемости.
Происходит выпадение волос, развивается кровоточивость дёсен. Проблемы с кожей становятся постоянными. Вследствие ломкости капилляров возникают кровоизлияния под кожным покровом и на слизистых. При незначительном воздействии на любую часть тела появляются синяки.
Почувствовать дефицит витаминов можно в холодное время года, когда происходит малое потребление растительных продуктов. Особенно страдает организм от недостаточного количества аскорбиновой кислоты. Приём препаратов не помогает, так как сокращено поступление витамина Р, который действует совместно с витамином С.
От этого страдает весь организм, иммунитет резко снижается, что делает человека доступным для различного вида инфекций, склонным к простудам
Важно в это время стараться увеличить приём препаратов, содержащих оба компонента
История биотина, из которой мы узнаем, что не так с сырыми яйцами
Биотин начали изучать только в XX веке, а именно – в 1916 году, когда американский ученый У. Бейтман обнаружил, что диета с высоким содержанием сырых яичных белков вызывает токсические симптомы у животных и людей.
Спустя примерно десять лет биохимики Маргарет Боас и Хелен Парсонс провели ряд экспериментов с крысами, чтобы убедиться в правоте мистера Бейтмана, и выяснили, что яичный белок действительно оказывает влияние на метаболические процессы. Но какие именно? Это еще только предстояло узнать.
В 1936 году немецко-голландский биохимик Фриц Кёгль и его аспирант Бенно Тоннис из Утрехтского университета выделили кристаллическое вещество из вареных утиных яичных желтков, которое назвали «биотином», впервые задокументировав это название в своей статье «Представление кристаллизованного биотина из яичного желтка». Оказалось, что именно биотин «не любит» сырые яичные белки, из-за которых плохо усваивается, вызывая тем самым множество проблем со здоровьем.
Параллельно с Кёглем аналогичную работу вели венгерский ученый Пол Дьердь, который и назвал новое вещество «витамином Н» (помните, мы писали об этом в начале статьи?), а также американцы П. Уэст и П. Уилсон, выделившие соединение «коэнзим R».

Как вы понимаете, это был один и тот же биотин, который все ученые признали к 1940 году. Именно в то время впервые появились данные о том, сколько биотина/витамина Н/коэнзима R необходимо человеку в сутки.
В лабораторных условиях биотин был впервые синтезирован в 1943 году Лео Штернбахом и Моисеем Гольдбергом.
Кстати, братьям нашим меньшим тоже важно получать достаточное количество биотина, поэтому для кошек, собак, лошадей, коров и других домашних животных выпускаются свои биодобавки с этим витамином

Взаимодействие с другими лекарственными средствами
Янтарная кислота, инозин, никотинамид совместимы с другими лекарственными средствами. Рибофлавин уменьшает активность доксициклина, тетрациклина, окситетрациклина, эритромицина и линкомицина.
Несовместим со стрептомицином. Хлорпромазин, имипрамин, амитриптилин за счёт блокады флавинокиназы нарушают включение рибофлавина во флавинаденинмононуклеотид и флавинадениндинуклеотид
и увеличивают его выведение с мочой. Тиреоидные гормоны ускоряют метаболизм рибофлавина. Уменьшает и предупреждает побочные эффекты хлорамфеникола (нарушение гемопоэза, неврит зрительного нерва).
Совместим с препаратами, стимулирующими гемопоэз, антигипоксантами, анаболическими стероидами.
Рутин при геморрое
В проктологии витамин Р применяют для укрепления стенок сосудов и капилляров венозной «сети» прямой кишки. При лечении геморроидальных узлов чаще всего используют аскорутин или препараты рутина в комбинации с органическим витамином С (аскорбатом кальция). Совместное применение аскорбиновой кислоты и биофлавоноидов приводит к уменьшению отёчности и кровоточивости в кавернозной ткани, улучшению микроциркуляции крови в венозной сети прямой кишки. При этом, рутозид (гликозид флавоноида кверцетина) укрепляет венозную стенку геморроидальных узлов, подавляет воспалительные процессы в них, снижает проницаемость капилляров, препятствует тромбообразованию, а витамин С – участвует в образовании коллагена в клетках, синтезе белков и липидов, окислительно – восстановительных реакциях, метаболизме углеводов.
Комплексное воздействие веществ на капилляры прямой кишки – залог успешного устранения геморроидальных кровотечений и предупреждения их повторного развития в будущем.
Помимо этого, витамин Р помогает ликвидировать болевой синдром и отёчность, которые возникают при обострении патологии. При геморрое рутин применяют на всех стадиях заболевания, независимо от наружного или внутреннего расположения узла.
Во время «биофлавоноидной» терапии иногда возникают тошнота и головная боль, которые проходят спустя 5-7 дней.
Витамин Р, в составе аскорутина, назначают в дозировке – 50 миллиграмм (1 таблетка) 2 – 3 раза в день. Продолжительность лечения – 3 – 4 недели.
Препараты данной группы с осторожностью используют при тромбофлебитах и тромбозах
Инструкция к применению рутина
Биофлавоноиды – мощные антиоксиданты и капилляропротекторы, по фармакологическим свойствам сравнимые с аскорбиновой кислотой и токоферолом. Их используют для защиты клеток от свободных радикалов, повышения иммунитета, укрепления кровеносных сосудов, оздоровления организма.
Показания к применению:
- геморрагические диатезы (гемофилия, патология Шенлейн — Геноха, болезнь Верльгофа);
- гипо- и авитаминозы Р;
- поверхностные тромбофлебиты;
- геморрой;
- кровотечения различного генеза (желудочно-кишеные, носовые, легочные, глазные);
- геморрагии, сопутствующие инфекционным патологиям (скарлатине, кори, вирусным инфекциям);
- заболевания пищеварительного тракта (язва желудка или двенадцатиперстной кишки);
- аллергическое воспаление стенок сосудов (капилляротоксикозы);
- лучевая болезнь;
- гломерулонефрит с геморрагическим синдромом;
- коллагенозы;
- кожные болезни (мокнущие экземы, дерматиты, гемосидерозы, токсические эритемы);
- ревматизм;
- заболевания желчевыделительных органов;
- поражения капилляров на фоне приёма салицилатов, антикоагулянтов и мышьяксодержащих средств;
- отек Квинке;
- лимфостаз;
- венозная недостаточность нижних конечностей;
- септический эндокардит;
- гломерулонефриты;
- гипертоническая болезнь;
- тромбоцитопеническая пурпура;
- варикозное расширение вен.
Учитывая способность флавоноидов связывать медиаторы воспаления (гистамин и серотонин), провоцирующие появление болевого синдрома и отёка тканей, витамин Р в комбинации с аскорбиновой кислотой назначают при аллергии, бронхиальной астме, поллинозах, аллергических пищевых реакциях.
Инструкция по применению биофлавоноидных средств
Витамин Р (таблетки, капсулы, драже, порошок, гранулы) принимают внутрь после еды, распределяя дневную норму на 2 – 3 приёма.
Суточная потребность организма в витамине Р составляет:
- для грудничков и младенцев до 2 лет – 5 – 10 миллиграмм;
- для детей от 3 до 5 лет – 10 – 15 миллиграмм;
- для школьников от 6 до 8 лет – 15 – 20 миллиграмм;
- для подростков от 9 до 14 лет – 20 – 40 миллиграмм;
- для взрослых – 40 – 100 миллиграмм.
Средняя терапевтическая дозировка вещества – 150 миллиграмм в день. Однако, при хронической венозной недостаточности, диабетической ретинопатии, дерматологических реакциях на лучевую терапию, дневную порцию вещества допустимо повышать до 1200 миллиграмм (под наблюдением врача).
Противопоказания: первый триместр беременности, индивидуальная непереносимость вещества.
Помните, в ряде случаев усвоение флавоноидов протекает медленно и бессимптомно. Поэтому, при потребности приёма больших доз вещества (1000 миллиграмм), действие соединения усиливают органическим витамином С (в равной пропорции) и токоферолом. Рассмотрим факторы, которые провоцируют возникновение Р-недостаточности.
Взаимодействие экстракта флавоноидов и других веществ
На пороге открытия витаминных факторов, компонент Р вычеркнули из числа важнейших соединений, поскольку по мнению ученых, нутриент не принадлежал к числу незаменимых веществ для человеческого организма. Однако современные исследования, свидетельствуют об обратном, особенно, в поддержке резистентности капилляров, регуляции синтеза ферментов и клеточной защите от свободных радикалов.
Рассмотрим влияние и совместимость витамина Р на концентрацию других веществ.
- Кверцетин увеличивает биодоступность янтарной кислоты, L – карнитина и полиненасыщенных жирных кислот (омега 3).
- Витамин Р разрушается под воздействием кислорода, солнечного света и избыточного тепла.
- Алкоголь и никотин снижают концентрацию флавоноидов в организме в 3 раза.
- Рутин ослабляет фармакологические свойства витамина В1.
- Препарат Аскорутин, ввиду содержания аскорбиновой кислоты, усиливает абсорбцию железа и пенициллинов, уменьшает лечебное действие антикоагулянтов.
- Витамин Р усиливает терапевтические свойства цинка и селена.
- Концентрат биофлавоноидов препятствует окислению аскорбиновой кислоты, усиливая её фармакологические свойства в десятки раз.
- Витамин Р ускоряет абсорбцию бета – каротина в кишечнике.
- Под действием антибиотиков, салицилатов, глюкокортикостероидов и сульфаниламидных средств концентрат флавоноидов не усваивается.
- Вещества группы Р препятствуют развитию осложнений при приёме антикоагулянтов (синкумара, варфарина).
- Витамин Р при взаимодействии с углеводами, образует комплексные соединения – гликозиды, которые защищают организм от неблагоприятных воздействий внешней среды.
- Биофлавоноиды сочетаются друг с другом и органическими кислотами.
Помните, заморозка и тепловая обработка свежих продуктов на 90% снижает концентрацию витаминного соединения в пище.
Свойства витамина Р
Именно присутствие биофлавоноидов придаёт большинству фруктов, ягод, овощей характерный цвет — от жёлтого и оранжевого до красного. Кроме этого, установлено, что именно эти вещества придают им характерный аромат и вкус.
Свойства витамина Р достаточно хорошо изучены. Основное из них – предохранять капилляры от ломкости, что предотвращает кровоизлияния и образование синяков, кровоточивость дёсен, появление кровяной сетки на оболочке глаза. Кроме этого, он выполняет ещё ряд функций:
- стабилизирует артериальное давление;
- принимает участие в деятельности щитовидной железы;
- увеличивает сопротивление организма различным инфекциям;
- предохраняет витамин С и адреналин от окисления;
- активирует работу надпочечников.
Применение при высоком артериальном давлении
В Цитрамон инструкции повышает или понижает давление детально указаны все имеющиеся противопоказания к приему Цитрамона. В руководстве отмечается запрет на лечение при наличии постоянно повышенного внутричерепного давления. Прием усугубляет состояние, перед началом терапии необходимо провести лабораторно-диагностическое исследование и узнать, почему болит голова.
К медицинским признакам повышенного АД можно отнести:
- цефалгию — давяющую, тупую,
- нарушение остроты зрения с ощущением размытости,
- кровотечения из носа,
- головокружения.
При низком артериальном давлении появляются следующие симптомы:
- головокружения,
- краткосрочные обмороки,
- снижение зрения,
- слабость,
- рвота,
- тошнота.
Отдельные медицинские проявления наблюдаются как при высоком, так и низком АД
Чтобы грамотно оценить состояние, следует брать во внимание следующие данные:
- Использование средства разрешено — при бледности кожи, возникновении жажды и голода, озноба (лишь при низком внутричерепном давлении).
- Средство нельзя пить при симптомах гипертонического криза, с головными болями, пульсации в висках.
Терапия Цитрамоном в последней ситуации вызовет усугубление цефалгии. Лечение необходимо лишь при низком давлении, иначе реакция организма на средство будет непредсказуемой. Доктора рекомендуют бесконтрольно не пить любые препараты, в особенности, если чувствуется боль. Без диагностики и грамотного установления причин плохого самочувствия, можно сделать хуже, спровоцировать обострение скрытых патологических процессов. Головные боли патологического типа требуют комплексной терапии, а не временного гашения симптомов анальгетиками. Люди интересуются, Цитрамон от давления повышенного или пониженного? Если наблюдается пониженное давление, то данный препарат повышает его.
Витамин А: фрукты и овощи
- морковь
- брокколи
- болгарский перец
- тыква
- кайенский перец
- морковь
- дыня
- черешня
- абрикосы
- виноград
- шиповник
- зелень
- петрушка
- шпинат
- щавель
- мята
- шалфей
- хвощь
- лимонник
- подорожник
- крапива
- лопух
- листья малины
- фенхель
Крупы
Содержание ретинола в них незначительное и не способно покрыть суточную необходимость человека. Однако, если вы любите крупы и злаковые, вам стоит знать, что больше всего концентрация каратиноидов в овсянке.
Бобовые
Данный источник особенно важен для вегетарианцев, веганов или тех, кому нельзя употреблять животную пищу по состоянию здоровья.
- нут
- фасоль
- соя
- горох
Мясо
Давно известно, что самый полноценный и богатый источник витамина А – это говяжья печень. Также в меньших количестве он содержится в следующих продуктах:
- говядина
- куриное мясо
- морепродукты
- креветки
- моллюски
- икра рыб
- кальмары
Молочные продукты
- сыр
- сливки
- сливочное масло
- творог
- сметана
- молоко
- ряженка
- простокваша
- натуральные йогурты
Также из животных продуктов, в которых велико содержание каратиноидов относят куриные яйца. Особенно богаты ретинолом желтки.
Включайте в свой ежедневный рацион эти полезные и питательные продукты, и вы сможете защитить свой организм от многих заболеваний, улучшить общее состояние и самочувствие, ускорить обменные процессы в организме, избежать нарушений в функционировании нервной системы. Кроме того, не забывайте употреблять в пищу блюда, содержащие в достаточном объеме витамин Е, иначе каратиноиды не будут полноценно усвоены организмом. Многие растения и зелень содержат большое количество этого вещества. Также стоит выделить некоторые продукты, которые им особенно богаты:
- миндаль
- арахис
- растительные масла: кукурузное, льняное, подсолнечное
- овес
- рожь
- коричневый рис
Экспериментируйте, создавайте вкусные и полезные кулинарные сочетания, наслаждайтесь питательными и вкусными блюдами, ведь правильное питание вовсе не означает невкусное.
Частые вопросы про биотин
Все важное в этой статье мы уже рассказали, но напоследок ответим еще на несколько вопросов, которые у вас могли остаться. Можно ли пить биотин «про запас»?
Можно ли пить биотин «про запас»?
Нет. Биотин не накапливается в организме. И если этого витамина недостаточно в вашем рационе, его уровень может снизиться.
Какие органы в первую очередь нуждаются в биотине?
Биотин важен для кожи и ногтей, а также для здоровья глаз, печени и нервной системы.
Может ли биотин навредить?
Биотин – безопасный и нетоксичный витамин. Исследования не показали каких-либо серьезных побочных эффектов даже при применении больших доз.

Можно ли принимать биотин беременным и кормящим?
На сегодняшний день нет доказанных противопоказаний для приема биотина беременными и кормящими женщинами, но всегда лучше проконсультироваться со своим лечащим врачом.
Что делает биотин?
Биотин участвует в процессах метаболизма, расщепляя пищу на элементы, которые наше тело может использовать для получения энергии.
Когда лучше принимать биотин?
Биотин в качестве витаминной добавки можно пить в любое время дня, но желательно совместить это с приемом пищи.

Может ли биотин влиять на прием других лекарств?
Да, может. Именно поэтому в качестве медицинской добавки его должен назначать врач.
Какой биотин идеален волос?
Врачи считают, что лучше всего – получать биотин из продуктов, но и специальные витаминные добавки тоже прекрасно справятся со своей задачей.
Сколько времени нужно пить биотин для улучшения волос?
До того момента, пока анализы не покажут достаточно высокий уровень витамина в организме.
Какая должна быть дозировка для укрепления волос и ногтей?
Как правило, при видимых и подтвержденных анализами проблемах врачи назначают от 1000 до 10000 мкг в сутки.
В этом материале обобщены лучшие исследования доказательной медицины разных лет. Тем не менее он является ознакомительным и не может быть использован в качестве прямого руководства к действию. Перед употреблением добавок с биотином необходима консультация специалиста.
Инструкция по применению
Это вещество входит в состав различных средств, которые имеются в продаже. Его выпускают в форме гелей, гранул, жидкостей, таблеток. Продаётся также лецитин в капс.
Считается, что в жидком виде это вещество можно принимать вместе с пищей, смешав с ней. Самой востребованной формой является покупка в гранулах. В этом случае проще контролировать качество.
Суточная доза препарата в таблетках или гранулах для взрослого человека равна 5-6 граммов на протяжении суток. Для ребёнка она будет меньшей и составит 1-4 грамма. Однако речь идёт не о полной дозе, а только о той её части, которую получают вместе с едой, например, вместе с соевым лецитином.
Обычный курс лечения длится в течение трёх месяцев. В некоторых случаях длительность приёма порошков или гранул возрастает до нескольких лет. Продолжительность леччения должен определять врач.
Принимают лецитин во время приёма пищи трижды в день. Его принимают непосредственно перед едой. Допускается это делать одновременно. Нужно соблюдать срок годности препарата или витаминного комплекса. Если он нарушен, то лецитин приобретает прогорклый вкус подобно испорченному жиру. В таком случае его употреблять нельзя.
Способ применения и дозы
У взрослых
ЦИТОФЛАВИН применяют только внутривенно капельно в разведении на 100–200 мл 5–10 % раствора декстрозы или 0,9 % раствора натрия хлорида. Скорость введения 3–4 мл/мин.
1. При инфаркте мозга препарат вводят в максимально ранние сроки от начала развития заболевания в объёме 10 мл на введение с интервалом 8–12 часов в течение 10 дней. При
тяжёлой форме течения заболевания разовую дозу увеличивают до 20 мл.
2. При последствиях цереброваскулярных болезней (инфаркта мозга, церебрального атеросклероза) препарат вводят в объёме 10 мл на введение один раз в сутки в течение 10 дней.
3. При токсической и гипоксической энцефалопатии препарат вводят в объёме 10 мл на введение два раза в сутки через 8–12 часов в течение 5 дней. При коматозном состоянии –
в объёме 20 мл на введение в разведении на 200 мл раствора декстрозы. При посленаркозном угнетении сознания – однократно в тех же дозах. В терапии гипоксической энцефалопатии при кардиохирургических операциях с использованием искусственного кровообращения вводят по 20 мл препарата в разведении на 200 мл 5 % раствора декстрозы за 3 дня до операции, в день операции, в течение 3 дней после операции.
4. Для профилактики когнитивных расстройств после обширных хирургических вмешательств у пациентов пожилого возраста препарат вводят в объёме 20 мл на введение в разведении на 200 мл 0,9 % раствора натрия хлорида. Курс лечения – 7 дней по схеме: первое введение — за сутки до операции; второе – интраоперационное введение после осуществления вводного наркоза (начало инфузии в течение 30 минут от начала операции), затем в течение 5 дней после операции. В дальнейшем рекомендуется применение препарата «ЦИТОФЛАВИН таблетки, покрытые кишечнорастворимой оболочкой» по 2 таблетки 2 раза в сутки
с интервалом между приёмами 8–10 часов в течение 25 дней.
У детей (в том числе недоношенных) в периоде новорождённости с церебральной ишемией суточная доза препарата ЦИТОФЛАВИН составляет 2 мл/кг. Рассчитанную суточную дозу препарата вводят внутривенно капельно (медленно) после разведения в 5 % или 10 % растворе декстрозы (в соотношении не менее 1:5). Время первого введения – первые 12 часов после рождения; оптимальным временем для начала терапии являются первые 2 часа жизни. Рекомендуется вводить приготовленный раствор с помощью инфузионного насоса со скоростью от 1 до 4 мл/ч, обеспечивая равномерное поступление препарата в кровоток в течение суток, в зависимости от рассчитанного суточного объёма растворов для базисной терапии, состояния гемодинамики пациента и показателей кислотно-основного состояния. Курс лечения составляет в среднем 5 суток.
Витамин Р в природе
Биофлавоноиды содержатся в органеллах растений: листьях, корнях, цветках, плодах, древесине и клеточном соке (в растворённом виде). Наибольшее количество витамина Р сосредоточено в мякоти и кожице цитрусовых, розоцветных культурах, что придаёт им насыщенный бордовый, фиолетовый окрас (вишня, черника, слива).
В плодах некоторых растений флавоноиды сконцентрированы преимущественно в шкурке (яблоки, огурцы, груши). При этом, каждый продукт содержит исключительную композицию флавоноидов. Например, в свёкле присутствует бетаин и бетанин, в чернике – антоцианины, в цитрусовых – флавоны и флавононы, в чае (зелёном) – катехины.
| Наименование продукта | Содержание флавоноидов в 100 граммах продуктов, миллиграмм |
|---|---|
| Черноплодная рябина | 3000 |
| Вишня | 2300 |
| Жимолость | 1300 |
| Шиповник (плоды) | 1000 |
| Лимон, апельсин | 500 |
| Щавель | 450 |
| Виноград | 430 |
| Барбарис | 400 |
| Нектарин, персик | 350 |
| Болгарский перец | 300 |
| Черника | 300 |
| Крыжовник, ёшта | 300 |
| Земляника | 300 |
| Клубника | 250 |
| Брусника | 250 |
| Малина | 250 |
| Чёрная смородина | 240 |
| Красная смородина | 210 |
| Айва | 205 |
| Капуста белокочанная | 160 |
| Капуста цветная | 140 |
| Картофель (молодой) | 100 |
| Салат листовой, шпинат | 90 |
| Слива | 90 |
| Черешня | 85 |
| Яблоко | 80 |
| Помидор | 60 |
| Соевые бобы | 56 |
| Кедровый орех | 48 |
| Фундук | 40 |
| Кунжут (злак) | 34 |
Хорошо восполняют запасы витамина Р отвары из трав: хвоща, боярышника, чайного листа, горца, солодки, бессмертника, пижмы, пустырника, гибискуса (каркаде). При этом концентрация флавоноидов в чашке напитка составляет от 40 до 400 миллиграмм, в зависимости от вида сырья и способа запаривания.
Полезные свойства и его влияние на организм
Основные функции витамина Р — укрепление капилляров и снижение проницаемости
сосудистой стенки. Он предотвращает и излечивает
кровоточивость десен, предупреждает кровоизлияния,
оказывает антиоксидантное действие.
Биофлавоноиды стимулируют тканевое дыхание и
деятельность некоторых эндокринных желез, в частности
надпочечников, улучшают работу щитовидной железы,
повышают устойчивость к инфекциям и снижают кровяное
давление.
Биофлавоноиды положительно действуют на сердечно-сосудистую
систему: улучшают кровообращение и тонус сердца,
предупреждают атеросклероз, стимулируют функции
лимфовенозного сектора сосудистой системы.
Биофлавоноиды растений при регулярном их приеме
снижают риск развития ишемической болезни сердца,
инфаркта миокарда, внезапной смерти, гипертонической
болезни.
Для чего нужен витамин P
Особенностью флавоноидов является их сопутствие витамину С и способность этих двух групп усиливать действие друг друга
Людям важно знать для чего нужен витамин P:
- Препятствует разрушению гиалуроновой кислоты, которая связывает клетки сосудов. С помощью кислоты и витамина запускается процесс снижения проницаемости сосудов, укрепления их структуры, поддержания эластических свойств и способности расширяться. Этот механизм предотвращает хрупкость сосудов, образование кровоизлияний, варикоза, геморроя.
- Препятствует слипанию тромбоцитов и тромбообразованию, поэтому витамин рутин используют в лечении гипертонии, болезней сердца, варикоза.
- Отличается сильным антиоксидантным действием, предотвращает окисление витамина С, связывает свободные радикалы, выводит из организма токсины, поддерживает хорошее состояние кожи, волос, замедляет старение организма. Биоактивный комплекс оказывает пользу при лечении онкозаболеваний.
- Обладает способностью воздействовать на синтез надпочечниками глюкокортикоидов, которые стимулируют защитные силы организма для борьбы с воспалительными процессами в организме. При возникновении очагов воспаления способствует оттоку крови от них, снимает боль и выводит токсины (продукты распада). Катехин обладает свойством восстанавливать структуру клетки.
- При аллергических заболеваниях, бронхиальной астме ускоряет и смягчает процесс течения болезни. Витаминный комплекс влияет на иммунную систему, регулирует выработку гистамина и серотонина и уменьшает раздражительное действие аллергенов.
- Обладает легким диуретическим действием, желчегонным действием. Его назначают при заболеваниях печени, желчного пузыря.















